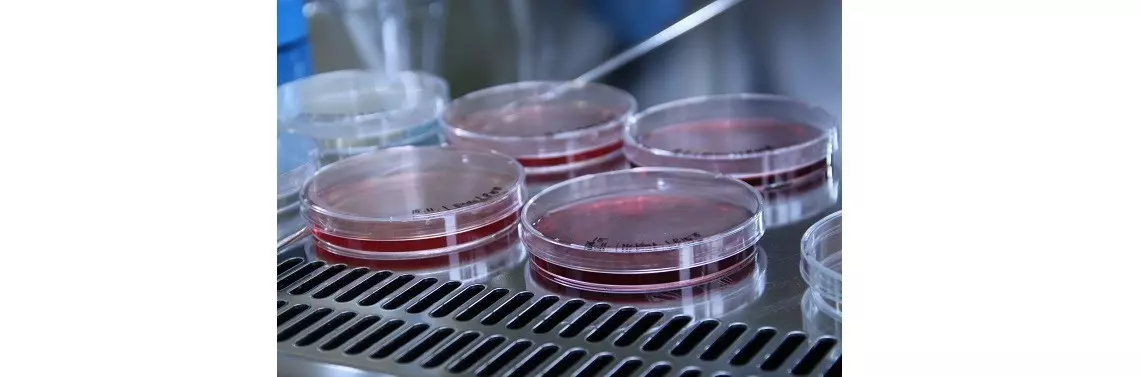

Novel food z Polski
Yarrowia lipolytica jest specjalnym szczepem drożdży o wyjątkowych właściwościach i zarazem innowacyjnym produktem żywnościowym należącym do kategorii Novel Food. Szczep ten został wyizolowany przez zespół profesora Waldemara Rymowicza z Uniwersytetu Przyrodniczego we Wrocławiu. Zespół ten zajmuje się wykorzystaniem drożdży z gatunku Yarrowia lipolytica do różnych zastosowań w biotechnologii od 30 lat.
POLECAMY
Yarrovia lipolytica Novel Food (YL)
Unia Europejska w odpowiedzi na postępujący wzrost popularności nowych rozwiązań w zakresie żywności stworzyła regulacje, którym podlegają nowe produkty żywieniowe (określane jako NOVEL FOOD, z ang. nowa żywność), w taki sposób, aby były one korzystne i bezpieczne dla nas wszystkich.
Novel Food to rodzaj żywności, która definiowana jest jako żywność innowacyjna, stworzona z pomocą nowoczesnych technologii i procesów produkcyjnych. Żywność tego typu podlega ściśle określonym regulacjom prawnym, a wprowadzenie produktu mogącego określać się jako Novel Food wymaga przejścia długiego i rygorystycznego procesu certyfikującego.
Yarrowia lipolytica, która szczyci się mianem produktu Novel Food, jest jednym z niekonwencjonalnych szczepów drożdży, produktem gruntowanie przebadanym przed jednostki naukowo-badawcze (w Polsce m.in. Instytut Żywności i Żywienia im. Prof. Dr. Med. Aleksandra Szczygła).
Yarrowia lipolytica Novel Food (YL) to dezaktywowany szczep drożdży z rodziny Saccharomyces, który charakteryzuje się zdolnością do metabolizowania nietypowych źródeł węgla, produkcją kwasów organicznych, witamin, substancji bioaktywnych oraz wysoką aktywnością proteolityczną (rozkład białek na peptydy i aminokwasy) i lipolityczną (rozkład tłuszczy). Dzięki temu umożliwia lepszy dostęp do ww. składników w formie podstawowej, przez co są one łatwiej wchłaniane przez nasz organizm. Dodatkowo Yarrowia lipolytica Novel Food (YL) wykazuje większą zawartość białka i wartościowych tłuszczy. Dzięki temu ma wyższą wartość odżywczą niż bardziej poznana i szeroko stosowana w przemyśle spożywczym odmiana należąca do tej samej rodziny co Yarrovia lipolytica Novel Food (YL), Saccharomyces cerevisiae.
Yarrowia lipolytica Novel Food (YL) jest źródłem naturalnych witamin z grupy B (m.in. B1, B6, biotyna, kwas foliowy i B12), witamin C, D i E oraz mikroelementów niezbędnych do prawidłowego funkcjonowania organizmu (Zn, Se, Mg, K, Ca, Cr, Fe, Cu). Zawiera wyjątkowy błonnik z wysoką zawartością Beta-glukanów (25-30%), a frakcja tłuszczowa charakteryzuje się wysokim udziałem tłuszczów nienasyconych (ponad 90% ogólnej zawartości dobrych tłuszczy). Dzięki swojemu bogatemu składowi, drożdże Yarrovia lipolytica Novel Food (YL) wykazują wysoką gęstość odżywczą, tzn., że niskiej wartości energetycznej (kalorycznej) towarzyszy ogromna ilość składników odżywczych o funkcjach niezbędnych i kluczowych dla naszego organizmu.
Yarrowia lipolytica Novel Food (YL) nie jest modyfikowana genetycznie, nie zawiera glutenu, dodatku cukru, barwników czy konserwantów. Jest naturalną, kompletną skarbnicą składników odżywczych, minerałów, witamin oraz związków bioaktywnych, która ma wpływ budowanie odporności i opóźnianie procesów starzenia.

- Od samego początku wiedzieliśmy, że Yarrowia lipolytica stanie się istotnym składnikiem produktów żywnościowych w kategorii tzw. super foods. Dzięki jej wykorzystaniu konsumenci mają szanse na wspieranie i budowanie odporności organizmu, skuteczne zarządzanie bilansem kalorycznym, kontrolowanie jakości posiłków, dbanie o swoją kondycję psychiczną i fizyczną, opóźnianie oznak starzenia itd. – mówi Jacek Kostrzewa Prezes Skotan S.A. – Dlatego bardzo nas cieszy, że dzięki współpracy z Life Beauty Pharma, klienci niebawem będą mogli korzystać z jej unikalnych właściwości, sięgając po produkty w kategorii „meal replacement”, w którego składzie znajdzie się Yarrowia lipolytica – dodaje.

Produkty od Life Beauty Pharma
Misją Life Beauty Pharma jest stwarzanie konsumentom na całym świecie dostępu do najlepszych produktów z kategorii health&beauty pochodzenia naturalnego. Wszystkie produkty powstają na podstawie wyników badań naukowych i zachowaniem najwyższych standardów produkcji. Do tego są w 100% naturalne oraz zawierają tylko najwyższej jakości składniki.
- Poszukując innowacyjnego składnika, który będzie odpowiedzią na współczesne, istotne potrzeby konsumentów, czyli budowanie odporności i opóźnianie procesów starzenia – trafiliśmy na Yarrowia lipolytica Novel Food. Prawie rok pracowaliśmy w laboratorium nad stworzeniem odpowiedniej formuły produktu, który ma szansę zapewnić konsumentom najwyższą dostępność do wartości odżywczych, najlepszy smak i najwyższą jakość w tej kategorii – mówi Krzysztof Kozak, Prezes Zarządu w Life Beauty Pharma.
#####
Więcej informacji na: